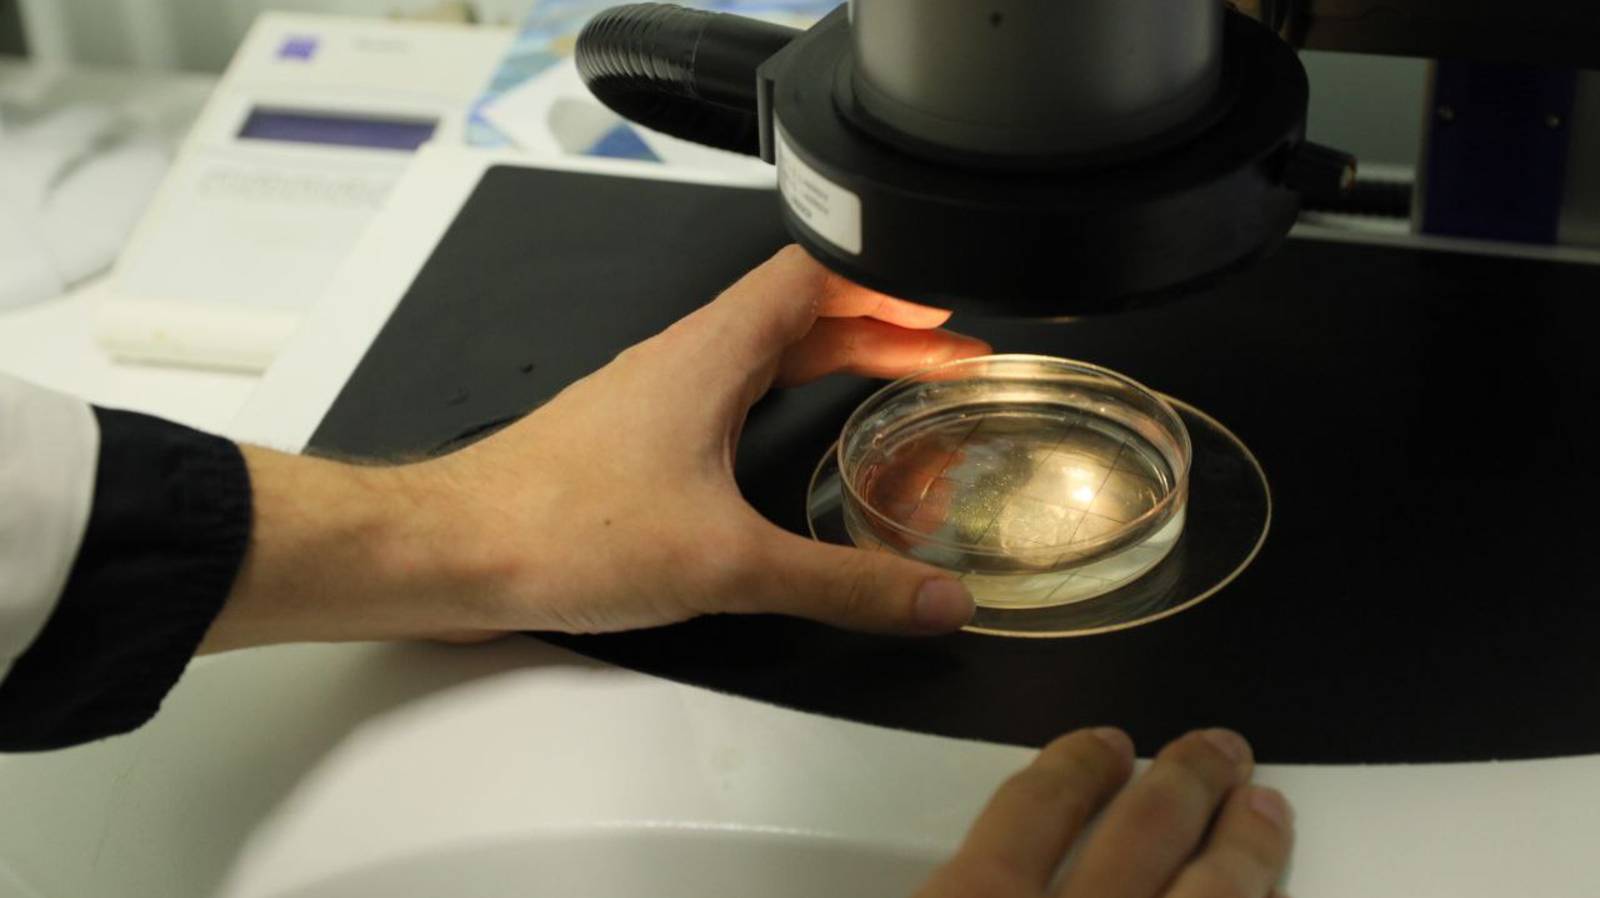
Как работает память? Студенческий тур «Научной России» в ИВНД и НФ РАН

- Лайфстайл
- Недвижимость
- Здоровье
- Природа
- Дизайн
- Техника и оборудование
- Бизнес и предпринимательство
- Искусство
- Религия
- Строительство и ремонт
- Сад и огород
- Аудиокниги
- Кулинария
- Интервью
- Развлечения
- Лайфхаки
- Эзотерика
- Охота и рыбалка
- Наука
- Политика
- Психология
- Аудио
- Технологии и интернет
- Красота
- Телепередачи
- Детям
- Аниме
- Хобби
- Видеоигры
- Юмор
- Образование
- Спорт
- Разное
- Путешествия
- Животные
- Новости и СМИ
- Мультфильмы
- Музыка
- Сериалы
- Фильмы
- Авто-мото
«Большие электрические мощности вторгаются в нашу жизнь»
О самых актуальных научных разработках, в частности о том, зачем нужно изучать магнитосферу Земли и вредят ли нам магнитные бури, рассказывает директор Института космических исследований РАН член-корреспондент РАН Анатолий Алексеевич Петрукович.
Анатолий Алексеевич Петрукович – специалист в области космической плазмы и геофизики, доктор физико-математических наук. В ходе экспериментальных исследований ученый получил ряд важных результатов. В частности, была построена новая модель разрушения слоя в ходе цикла накопления энергии, разработана модель зондовых измерений переменных электрических токов в околоземной плазме, открыт и изучен ряд новых глобальных эффектов и структур в магнитосфере Земли. В 1990–2000 гг. ученый принимал участие в российских и международных космических проектах «Интербол», Geotail, Cluster. Руководил разработкой и проведением экспериментов на российских КА «Спектр-Р», «Резонанс», «Луна-Глоб». Является представителем РФ в координационной группе космических агентств по солнечно-земной физике (ILWS).
Интервью проведено при поддержке Министерства науки и высшего образования РФ
Полный текст интервью по ссылке: https://scientificrussia.ru/articles/bolsie-elektriceskie-mosnosti-vtorgautsa-v-nasu-zizn
Беседовала Наталия #Лескова
Фотограф Елена #Либрик
Оператор Александр #Козлов
Оператор Яна #Куль
#scientificrussia #Магнитное_поле #магнитная_буря #магнитосфера #полярное_сияние
Видео «Большие электрические мощности вторгаются в нашу жизнь» автора Научная Россия / Scientific Russia
Видео «Большие электрические мощности вторгаются в нашу жизнь» автора Научная Россия / Scientific Russia
Информация
21 мая 2025 г. 11:16:10
00:24:59
Похожие видео